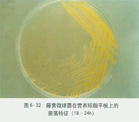
肉毒梭菌C型

基本概述
肉毒梭菌屬於厭氧性梭狀芽胞桿菌屬,具有該菌的基本特性,即厭氧性的桿狀菌,形成芽胞,芽胞比繁殖體寬,呈梭狀,新鮮培養基的革蘭氏染色為陽性,產生劇烈細菌外毒素,即肉毒毒素。 肉毒梭菌生長時,可形成一種強力的毒素抑制呼吸導致死亡,這是迄今為止所知的最毒的自然生成的毒素之一。
 肉毒梭菌
肉毒梭菌類型
一種是蛋白分解型(就是分解蛋白質的類型),另一種是非蛋白分解型(就是不能分解蛋白質的類型)。蛋白分解型包括肉毒梭菌的A型和一部分B型和F型。非蛋白分解型包括肉毒梭菌的E型和一部分B型和F型。
生物形態
肉毒梭菌為多形態細菌,約為4×1μm的大桿菌,兩側平行,兩端鈍園,直桿狀或稍彎曲,芽胞為卵圓形,位於次極端,或偶有位於中央,常見很多游離芽胞。有時形成長絲狀或鏈狀,有時能見到舟形、帶把柄的檸檬形、蛇樣線裝、染色較深的球莖狀,這些屬於退化型。當菌體開始形成芽胞時,常常伴隨著自溶現象,可見到陰影形。肉毒梭菌具有4-8根周毛性鞭毛,運動遲緩;沒有莢膜。
生物觀察
在固體培養基表面上
形成不正圓形,大約3毫米左右的菌落。菌落半透明,表面呈顆粒狀,邊緣不整齊,界線不明顯,向外擴散,呈絨毛網狀,常常擴散成菌苔。在血平板上
出現與菌落幾乎等大或者較大的溶血環。 肉毒梭菌
肉毒梭菌在乳糖卵黃牛奶平板上
菌落下培養基為乳濁,菌落表面及周圍形成彩虹薄層,不分解乳糖;分解蛋白的菌株,菌落周圍出現透明環。適宜溫度
肉毒梭菌發育最適溫度為25-35℃,培養基的最適的酸鹼度為pH6.0-8.2。生化性狀
肉毒梭菌的生化性狀很不規律,即使同性,也常見到株間的差異2、肉毒梭菌的致病性流行病學
肉毒梭菌廣泛存在於自然界,引起中毒的食品有臘腸、火腿、魚及魚製品和罐頭食品等。在美國以罐頭髮生中毒較多,日本以魚製品較多,在我國主要以發酵食品有關,如臭豆腐、豆瓣醬、面醬、豆豉等。其它也引起中毒的食品還有:熏制未去內臟的魚、填餡茄子、油浸大蒜、、烤土豆、炒洋蔥、蜂蜜製品等。
肉毒梭菌是致死性最高的病原體之一。感染劑量極低,每個人都易感。攝食18-36小時後發病為典型病症,但不典型的可在4小時至8天不等。症狀為虛弱、眩暈、伴隨視覺成雙、漸進性說話障礙、呼吸和吞咽困難。也許會出現腹脹和便秘。毒素最終引起麻痹,呈漸進對稱性、自上到下
肉毒梭菌在自然界的分布上具有某種區域性差異,顯示出生態上的差別傾向。A、B型的分布最廣其芽胞廣泛分布於自然界,各大洲的許多國家均有檢出,;C、D型的芽胞一般多存在於動物的屍體中,或在腐屍附近的土壤中;E型菌及其芽胞存在於海洋的沉積物、水產品的腸道內,E型菌及其芽胞適應於深水的低溫,使E型菌在海洋地區的廣泛分布。但是,越來越多的調查結果表明,除G型菌之外,其它各型菌的分布都是相當廣泛的。
致病性
肉毒梭菌的致病性在於所產生的神經毒素即肉毒毒素,這些毒素能引起人和動物的肉毒中毒,根據肉毒毒素的抗原性,肉毒梭菌至今已有A、B、C(1、2)、D、E、F、G等七個型。引起人群中毒的,主要有A、B、E三型。C、D二型毒素主要是畜、禽肉毒中毒的病原。F、G型肉毒梭菌極少分離,未見G型菌引起人群的中毒報導。
肉毒毒素
生物學性狀
肉毒梭菌的致病性在於其產生的神經麻痹毒素,即肉毒毒素,而細菌本身則是一種腐生菌。各個型的肉毒梭菌分別產生相應的毒素,所以,肉毒毒素也分為A、B、C、D、E、F、G等七個型。C型包括C1、C2二個亞型。
A型毒素經60℃2分鐘加熱,差不多能被完全破壞,而B、E二型毒素要經70℃2分鐘才能被破壞;C、D二型毒素對熱的抵抗更大些;C型毒素要經過90℃2分鐘加熱才能完全破壞,不論如何,只要煮沸1分鐘或75℃加熱5-10分鐘,毒素都能被完全破壞 。
肉毒梭菌C型
肉毒梭菌C型肉毒毒素對酸性反應比較穩定,對鹼性反應比較敏感。某些型的肉毒毒素在適宜條件下,毒性能被胰酶激活和加強。
致病性
肉毒毒素的毒性極強,是最強的神經麻痹毒素之一,據稱,精製毒素1微克的毒力為200,000小白鼠(20克)致死量,也就是說,1克毒素能殺死400萬噸小白鼠,一個人的致死量大概1微克左右。
致病物質
芽胞污染食品後,在厭氧條件下發芽生長,產生外毒素即肉毒毒素,為其主要致病物質。肉毒毒素是已知最劇烈的神經外毒素。毒素作用於中樞神經系統,影響神經衝動傳遞,導致肌肉弛緩型麻痹。
所致疾病
毒素經腸道吸收,進入血流,作用於顱腦神經核、外周神經-肌肉接頭處,阻礙乙醯膽鹼的釋放,導致肌肉遲緩型麻痹即肉毒中毒。
流行病學
肉毒中毒是由於誤食含有肉毒毒素的食品而引起的純粹的細菌毒素食物中毒。人的肉毒中毒發生並不多,但是發病急、病程發展快、病死率高。肉毒中毒是毒素中毒,潛伏期較短,一般為6至36小時,最長60小時。主要症狀有:視力減弱、全身無力、伸舌和張口困難、抬頭費力、瞳孔散大、呼吸麻痹等。
據統計,1899年至1990年,在美國共有2305人中毒,經檢測,303人感染A型毒素,92人感染B型毒,3人感染E型毒素,2人感染F型毒素,有2起中毒事件是由A、B二種毒素引起。F、G二種毒素,主要引起動物肉毒中毒,尚未深入得到研究。
重症患者,如果不及時治療和抗毒素特異治療,多在2至4天死亡。肉毒梭菌生長和產毒的最適溫度是25至30℃,而在人的體溫條件下細菌表現為絲狀,幾乎不能產毒、芽胞也不會發芽。
肉毒中毒一年四季均可發生,發病主要與飲食習慣有著密切關係。歐美國家主要的中毒是由於肉類食品、罐頭食品引起;日本等沿海國家主要的中毒是由於進食水產品引起;我國內地的中毒主要是由於進食發酵食品(如:臭豆腐、豆瓣醬、豆豉等)引起的。
肉毒毒素檢出及肉毒梭菌檢驗
A、肉毒毒素的檢出
肉毒中毒的診斷,重要的是毒素的檢出及定型;罐頭食品的細菌學檢驗,有時需要證實肉毒梭菌的存在,不過,最終還是要根據產毒試驗來鑑定細菌及其型別。
B、肉毒毒素檢測的主要程式
 肉毒梭菌
肉毒梭菌檢驗樣品經適當處理後取上清夜,用明膠磷酸緩衝液稀釋(1:5、1:10、1:100三個稀釋度)後各取0.5毫升腹腔注射小白鼠;另取上清夜100℃10分鐘加熱後注射小白鼠;另取上清夜經胰酶處理後注射小白鼠;每個注射樣注射二隻小白鼠;注射後,定時觀察小白鼠,連續觀測48小時;排除24小時後死亡的白鼠和無症狀死亡的小白鼠;48小時後,如果除了經熱處理後再注射樣品的小白鼠未死亡,其餘小白鼠均死亡的情況,重複試驗,增加稀釋倍數,計算最底致死量。並進行抗毒素中和試驗。
2.中和試驗用無菌生理鹽水溶解凍乾的抗毒素,,取A、B、E、F四種抗毒素注射於小白鼠體內;同時取未注射抗毒素的小白鼠做對照;注射抗毒素30分鐘或1小時後,注射不同稀釋度(覆蓋10、100、1000倍最小致死量)的含毒素樣品,觀察48小時,如發現毒素未被中和,再取C、D型抗毒素和A-F多價抗毒素重複上述試驗;如小白鼠死亡,應將含毒素樣品稀釋後再重複以上試驗。
3.試驗的幾個注意事項3.1典型的肉毒中毒,小白鼠會在4至6小時內死亡,而且98-99%的小白鼠會在12小時內死亡,因此,試驗前24小時內的觀察是非常重要的。
3.224小時後的死亡是可疑的,除非有典型的症狀出現。
3.3如果小白鼠注射經1:2或1:5倍數稀釋的樣品後死亡,但注射更高稀釋度的樣品後未死亡,這也是非常可疑的現象,一般為非特異性死亡。
3.4小白鼠要用不會抹去的顏料加以標記。
3.5小白鼠的飼料與水必須及時添加、充分供應。
4.1食物中發現毒素,表明未經充分的加熱處理,可能引起肉毒中毒。
4.2檢出肉毒梭菌,但未檢出肉毒毒素,不能證明此食物會引起肉毒中毒。
4.3肉毒中毒的診斷必須以檢出食物中的肉毒毒素為準。
4.4中和試驗可以為毒素定型。
C、肉毒梭菌的檢驗與分離鑑定
肉毒梭菌檢驗方法的重點乃是產毒及毒素的檢出試驗,如要證實是否有肉毒梭菌存在,只要分離、培養、毒素鑑定即可。
1.前增菌
樣品分別接種於皰肉培養基、TPGYT培養基,並分別與35、26℃培養7天。
2.分離
培養7天后,染色、鏡檢,觀察菌的形態是否為典型的肉毒梭菌。取1-2毫升培養物加等量的酒精混合(或80℃加熱10分鐘,)後在室問溫下培養1小時,非蛋白分解型的肉毒梭菌,因其芽胞不耐熱,不要採取熱處理的方法。
用接種環塗劃酒精處理液或熱處理的培養物於小牛肝卵黃瓊脂或厭氧卵黃瓊脂平板上,厭氧培養48小時,35℃。
典型菌落是隆起或扁平,光滑或粗糙,在卵黃培養基上用斜光檢驗時菌落表面通常出現虹暈色(iridescence),此光區稱為“珍珠層”,C、D、E型菌通常有2-4毫米黃色沉澱區圍繞,A、B型菌通常顯示較小的沉澱區。
挑取10個典型菌落,分別接種於皰肉培養基、TPGYT培養基,並分別與35、26℃培養7天,再取培養物按照1.2.1、1.2.2的方法進行肉毒毒素的檢測即可。
生化反應試驗,可以為鑑定做參考,以上肉毒梭菌的培養、分離、鑑定試驗力求迅速,不要長時間接觸空氣,最好在厭氧條件下操作。
食物中毒
肉毒梭菌毒素食物中毒(毒素型):
(1)病原:肉毒梭菌毒素(肉毒毒素)。
①嗜神經毒素(最強的生物毒素),分8型,A、B、E、F四型引起人類中毒;
②對酸、消化酶穩定,對鹼、熱不穩定,75~85℃,5~15分鐘或100℃1分鐘即被破壞;
③肉毒梭菌芽孢耐熱(濕熱100℃,5h、乾熱180℃,5~15min);
④各型毒素只能由同型的抗毒素中和,無交叉免疫。
(2)中毒食物:家庭自製穀物或豆類發酵製品。
①如臭豆腐、豆醬、面醬、豆豉等;
②食物中肉毒梭菌主要來源於帶菌土壤、塵埃及糞便。
(3)中毒機制:
①作用於外周神經-肌肉接頭處、植物神經末梢、顱腦神經核,阻斷乙醯膽鹼(Ach)釋放,造成運動神經麻痹,使神經衝動向肌肉的傳遞受阻,導致肌肉麻痹、癱瘓。
(4)症狀
①運動神經麻痹的症狀,而胃腸道症狀少見;
②潛伏期6小時~10天(1~4天);
③對稱性顱腦神經受損症狀:
眼部→咽部→頸部→呼吸肌;
④神志清楚、不發熱、脈搏快;
⑤病死率30%以上。
(5)治療
採用多價抗毒素血清治療,4~10天后恢復,病死率可降至10%左右。
防治方法
最根本的預防方法是加強食品衛生管理,改進食品的加工、調製及儲存方法,改善飲食習慣,對某些水產品的加工可採取事先取內臟,並通過保持鹽水濃度為10%的醃製方法,並使水活度低於0.85或pH為4.6以下,以及對於在常溫儲存的真空包裝食品採取高壓殺菌等措施,以確保抑制肉毒梭菌產生毒素,杜絕肉毒中毒病例的發生。
盤點鮮為人知的微生物
| 微生物是一切肉眼看不見的或看不清的微小生物的總稱。包括細菌、病毒、真菌以及一些小型的原生動物、顯微藻類等在內的一大類生物群體,它個體微小,卻與人類生活關係密切。 |
